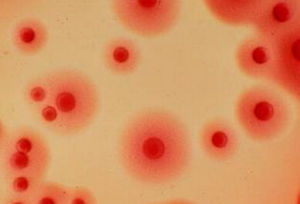
砂眼衣原體 砂眼衣原體

簡介
衣原體(chlamydia)包括沙眼衣原體(C.trachomatis)、鸚鵡熱衣原體(C.psittaci)和肺炎衣原體(C.pneumonia)3種。沙眼衣原體又分為沙眼、性病淋巴肉芽腫(lymphogranulomavenereum,LGV)和鼠生物變種3個生物變種。沙眼衣原體生物變種有A~K18個血清型,其中A、B、Ba、C引起沙眼,D~K型引起泌尿生殖道感染,如包涵體結膜炎、非淋菌性尿道炎、宮頸炎、輸卵管炎、附睪炎、直腸炎、新生兒肺炎和中耳炎等。衣原體性泌尿生殖道炎是目前世界最多的性病之一。性病淋巴肉芽腫變種有L1、L2、L2a、L34個血清型,可引起性病淋巴肉芽腫。鼠生物變種不引起人的疾病。鸚鵡熱衣原體和肺炎衣原體引起呼吸道感染,特別是肺炎。正常值
1∶8(補體結合試驗CF)。
<1∶32(間接螢光抗體法IFA)。
陰性(聚合酶鏈反應法PCR、酶聯免疫吸附分析法ELISA、免疫螢光測定法)。
臨床意義
(1)CF法:1∶128~256,性病、淋巴肉芽腫。
(2)IFA法:1∶64,沙眼衣原體引起的生殖器疾病。
>1∶4000,性病、淋巴肉芽腫。
(3)陽性:性病淋巴肉芽腫、沙眼、成人包涵體結膜炎、非淋病菌性尿道炎、新生兒結膜炎、附睪炎、直腸炎、前列腺炎、宮頸炎、輸卵管炎、子宮內膜炎。
生物學特性
(一)形態與染色
將雞胚卵黃囊或細胞培養的沙眼衣原體高度提純,於電鏡下檢查,可見原體呈球形或類球形,胞漿膜外有剛性細胞壁,壁外有平滑表層。始體的體積較大,形狀不甚規則,其包膜富有韌性,無剛性的細胞壁,原體和始體內皆含有DNA與RNA。
沙眼衣原體具有特殊的染色性狀,不同的發育階段其染色有所不同。成熟的原體以Giemsa染色為紫色,與監色的宿主細胞漿呈鮮明無比。始體以Giemsa染色呈藍色。沙眼衣原體對革蘭氏染色雖然一般反應為陰性,但變化不恆定。沙眼包涵體在上皮細胞漿內,很緻密,如以Giemsa染色,則呈深紫色,由密集的顆粒組成。其基質內含有糖原,以Lugol液染色呈棕褐色斑塊。
(二)培養
人類是沙眼衣原體的自然宿主。它主要寄生於機體黏膜上皮細胞。猴和猩猩的眼及泌尿系可實驗感染各型沙眼衣原體(包括LGV在內)。靈長類外的動物,對LGV之外的其他沙眼衣原體均無致病性。雞胚只對大多數沙眼衣原體敏感,但禽類則對各型沙眼衣原均不敏感。小白鼠對LGV衣原體是敏感的,尤其是腦內感染,病死率可達30%。此外,大白鼠、豚鼠和家兔對LGV衣原體的敏感性幼齡高於成年。所有沙眼衣原體都能在雞胚卵黃囊內生長繁殖,並致死雞胚。將沙眼衣原體懸液接種6~8天胚齡卵黃囊內,置35℃溫箱,一般於6~8天后死亡。剖檢時胚體及卵黃囊膜充血。卵黃囊膜塗片可散在衣原體,病理切片則可見卵黃囊膜細胞內包涵體。
所有沙眼衣原體均可在細胞培養中生長,現多採用McCoy或HeLa229細胞株,在接種衣原體前,以X線照射細胞,或於細胞培養中加入代謝抑制如細胞鬆弛素B、DEAE葡聚糖呈放線菌酮,其目的在於細胞生長代謝緩慢,以利於衣原體的寄生性生長。
所致疾病
(一)沙眼:由衣原體沙眼生物變種A、B、Ba、C血清型引起。主要經直接或間接接觸傳播,即眼~眼或眼~手~眼的途經傳播。當沙眼衣原體感染眼結膜上皮細胞後,在其中增殖並在胞漿內形成散在型、帽型、桑椹型或填塞型包涵體。該病發病緩慢,早期出現眼瞼結膜急性或亞急性炎症,表現流淚、有粘液膿性分泌物、結膜充血等症狀與體徵。後期移行為慢性,出現結膜瘢痕、眼瞼內翻、倒睫、角膜血管翳引起的角膜損害,以致影響視力,最後導致失明。據統計沙眼居致盲病因的首位。1956年我國學者湯飛凡等人用雞胚卵黃囊接種法,在世界上首次成功地分離出沙眼衣原體,從而促進了有關原體的研究。
(二)包涵體包膜炎:由沙眼生物變種D~K血清型引起。包括嬰兒及成人兩種。前者系嬰兒經產道感染,引起急性化膿性結膜炎(包涵體膿漏眼),不侵犯角膜,能自愈。成人感染可因兩性接觸,經手至眼的的途徑或者來自污染的游泳池水,引起濾泡性結膜炎又稱游泳池結膜炎。病變類似沙眼,但不出現角膜血管翳,亦無結膜瘢痕形成,一般經數周或數月痊癒,無後遺症。
(三)泌尿生殖道感染:經性接觸傳播,由沙眼生物變種D~K血清型引起。男性多表現為尿道炎,不經治療可緩解,但多數轉變成慢性,周期性加重,並可合併副睪炎、直腸炎等。女性能引起尿道炎、宮頸炎等,輸卵管炎是較嚴重併發症。該血清型有時也能引起沙眼衣原體性肺炎。
(四)性病淋巴肉芽腫:由沙眼衣原體LGV生物變種引起。LGV要通過兩性接觸傳播,是一種性病。男性侵犯腹股溝淋巴結,引起化膿性淋巴結炎和慢性淋巴肉芽腫。女性可侵犯會陰、肛門、直腸,出現會陰~肛門~直腸組織狹窄。
免疫性
機體感染衣原體後,能誘導產生型特異性細胞免疫和體液免疫。但通常免疫力不強,且為時短暫,因而常造成持續性感染、隱性感染和反覆感染。此外,也可能出現免疫病理損傷,由遲髮型超敏反應引起,如性病淋巴肉芽腫等。
微生物學診斷
多數衣原體引起的疾病可根據臨床症狀和體徵確診。但對早期或經症患者,須行實驗室檢查來幫助診斷。
(一)直接塗片鏡檢
沙眼急性期患者取結膜刮片,Giemsa或碘液及螢光抗體染色鏡檢,查上皮細胞漿內有無包涵體。包涵體結膜炎及性病淋巴肉芽腫,也可從病損局部取材塗片,染色鏡檢,觀察有無衣原體或包涵體。
(二)分離培養
用感染組織的滲出液或刮取物,接種雞胚卵黃囊或傳代細胞,分離衣原體,再用免疫學方法鑑定。
(三)血清學試驗
主要用於性病淋巴肉芽腫的輔助診斷。常用補體結合試驗,若雙份血清抗體效價升高4倍或以上者,有輔助診斷價值。也可用ELISA、凝集試驗。
(四)PCR試驗
設計不同的特異性引物,套用多聚酶鏈式反應可特異性診斷沙眼衣原體,具有敏感性高,特異性強的特點,現被廣泛套用。
防治原則
沙眼無特異的預防方法,疫苗在試用,效果不肯定。注意個人衛生,不使用公共毛巾和臉盆,避免直接或間接接觸傳染,是預防沙眼的重要措施。生殖道衣原體感染的預防同其他性病一樣。治療一般用利福平、四環素、氯黴素、強力黴素及磺胺等藥物。
盤點與我們一同生活的微生物
| 每個人都覺得自己是孤獨的,但全部知道有無數的細菌陪在我們的身邊,讓我們來好好認識一下它們吧! |